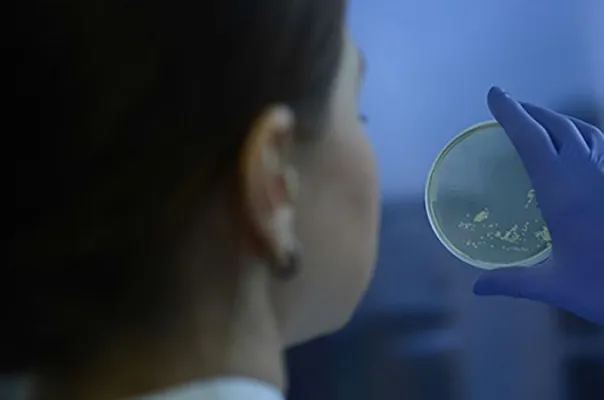
Wegweisende Kooperation: Fraunhofer initiiert deutsch-australisches Projekt iCAIR Bild: Wegweisende Kooperation: Fraunhofer initiiert deutsch-australisches Projekt iCAIR

(openPR) Zweiwertige Verbindung erstmals in reiner Form isoliert / Neue fundamentale Erkenntnisse liefern auch interessante Einblicke in die potenzielle Wirkungsweise von Gold(III)-Porphyrinen als Antitumormittel
---
Gemäß Lehrbuchmeinung bevorzugt Gold in seinen Verbindungen die Oxidationsstufen +I und +III. Die zweiwertige Form (+II) bildet dagegen mehrkernige Verbindungen oder wandelt sich in die ein- und dreiwertigen Formen um. Dies steht im Gegensatz zu den Nachbarelementen des Goldes: Hier liegen die Münzmetall-Ionen Kupfer(+II) und Silber(+II) in zweiwertiger Form vor, ebenso die linken und rechten Nachbarn Platin(+II) und Quecksilber(+II). In photochemischen Katalysereaktionen des Goldes wurde Gold(+II) zwar postuliert, ein hieb- und stichfester Nachweis war jedoch bislang nicht erbracht worden. Diesen Nachweis stellen nun Wissenschaftler der Johannes Gutenberg-Universität Mainz (JGU) in einer neuen Veröffentlichung vor.
Die Mainzer Chemiker unter der Leitung von Prof. Dr. Katja Heinze am Institut für Anorganische Chemie und Analytische Chemie haben einen Weg gefunden, Gold in der sehr seltenen Oxidationsstufe +II zu isolieren und zu charakterisieren. Damit wurden die Lücken in der homologen Reihe der Münzmetall-Ionen Kupfer(+II), Silber(+II), Gold(+II) und in der "relativistischen" Triade Platin(+II), Gold(+II), Quecksilber(+II) geschlossen. "Bislang unbekannte grundlegende Daten wie Ionengröße, bevorzugte strukturelle Anordnung und die Reaktivität von Gold(+II) sind nun zugänglich", erläutert Sebastian Preiß, Doktorand in der Arbeitsgruppe von Katja Heinze, der diese Gold(+II)-Verbindung erstmals in reiner Form isolieren konnte. Die Forschungsarbeit wurde in der Fachzeitschrift Nature Chemistry veröffentlicht.
Die Stabilisierung des sehr labilen Gold(+II)-Ions gelang den Forschern mithilfe eines sogenannten Porphyrins, das das Gold(+II)-Ion umschließt. Der Porphyrin-Makrozyklus ist als Baustein des Blattfarbstoffs Chlorophyll und des roten Blutfarbstoffs mit Magnesium- bzw. Eisenionen im Zentrum bekannt. Mit Gold(+II) im Zentrum unterdrückt das Porphyrin die typischen Reaktionspfade von Gold(+II), nämlich die Bildung mehrkerniger Verbindungen oder die Umwandlung in die stabileren Gold(+I)- und Gold(+III)-Verbindungen. "Somit war es erstmals möglich, diese neue, einzigartige Klasse von beständigen einkernigen Gold(+II)-Verbindungen näher zu untersuchen und vollständig zu beschreiben", fasst Katja Heinze zusammen. Bemerkenswerterweise ist die Anordnung der nächsten vier Atome um das Gold(+II)-Ion nicht wie bei den entsprechenden Verbindungen der Nachbarn Kupfer(+II), Silber(+II), Platin(+II) und Quecksilber(+II) quadratisch mit vier gleich langen Abständen zum Gold, sondern rautenförmig mit zwei kurzen und zwei langen Abständen. Im Fachjargon wird dieses bei Gold(II)-Ionen bislang nicht beobachtete Phänomen dem Jahn-Teller-Effekt zweiter Ordnung zugeschrieben, hervorgerufen durch die relativistischen Eigenschaften des Goldes.
Da diese neue Gold(+II)-Verbindung auch aus einer Gold(+III)-Verbindung erhalten werden kann, die als potentes Antitumormittel gilt, versuchten die Forscher zu ermitteln, ob das Gold(+II)-Porphyrin auch in biologischen Systemen eine Rolle spielen könnte. Tatsächlich kann die Gold(+II)-Verbindung unter nahezu physiologischen Bedingungen aus dem Gold(+III)-haltigen Zytostatikum erzeugt werden. Mit Luftsauerstoff bildet das Gold(+II)-Porphyrin reaktive Sauerstoffspezies (ROS). Von ROS wiederum ist bekannt, dass sie eine Apoptose, also den programmierten Zelltod, einleiten können. "Somit haben wir eine plausible Wirkungskette vom Zytostatikum bis zum gezielten Zelltod mit dem Gold(+II)-Porphyrin als wichtigem Kettenglied", freut sich Heinze. "Besonders der gelungene Brückenschlag von der durch Neugierde angetriebenen Grundlagenforschung über ungewöhnliche Verbindungen hin zu neuen Erkenntnissen in möglichen medizinischen Anwendungen ist für uns ein großer Ansporn, auf diesem Gebiet weiter zu forschen", ergänzt Heinze.
Abbildung:
http://www.uni-mainz.de/bilder_presse/09_anorgchemie_goldII.jpg
Gold in zweiwertiger Form ist im Zentrum von Porphyrinen stabil
Abb./©: Katja Heinze, JGU
Veröffentlichung:
Sebastian Preiß et al.
Structure and reactivity of a mononuclear gold(II) complex
Nature Chemistry, 7. August 2017
DOI: 10.1038/nchem.2836
http://www.nature.com/nchem/journal/vaop/ncurrent/full/nchem.2836.html
http://rdcu.be/uOqu
Kontakt und weitere Information:
Prof. Dr. Katja Heinze
Institut für Anorganische Chemie und Analytische Chemie
Johannes Gutenberg-Universität Mainz
55099 Mainz
Tel. +49 6131 39-25886
Fax +49 6131 39-27277
E-Mail:
https://www.ak-heinze.chemie.uni-mainz.de/
Weitere Informationen:
- http://www.uni-mainz.de/presse/aktuell/1802_DEU_HTML.php - "Molekulares Thermometer für kontaktlose Messungen mit infrarotem Licht", 07.06.2017
- http://www.uni-mainz.de/presse/aktuell/1212_DEU_HTML.php - "Johannes Gutenberg-Universität Mainz koordiniert neues DFG-Schwerpunktprogramm in der Photochemie", 19.04.2017
- http://www.uni-mainz.de/presse/63155.php - "Katja Heinze erhält Wissenschaftspreis für intelligente Lebensmittelverpackung mit Frischeanzeige", 24.11.2014
Quelle: idw